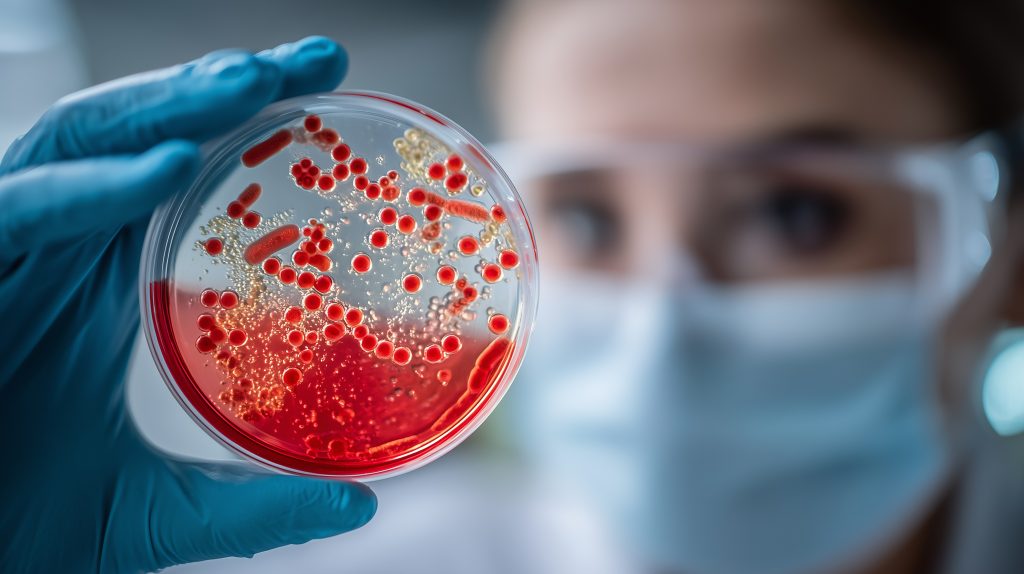

台新藥研發專案
Pipeline Overview
Double A 研發策略

台新藥的「Double A」研發策略聚焦於APNT與ADC兩大主軸:
- APNT®奈米微粒製劑技術:核心優勢為解決藥物難溶問題以提升吸收率。指標眼藥APP13007已成功取得美國藥證,該技術現正延伸應用至吸入劑與局部注射劑,並推動委託共同開發專案。
- ADC抗體藥物複合體(Antibody-Drug Conjugates):與台康生技與台耀化學聯盟合作,共同開發TSY-110與TSY-120兩款熱門的HER2生物相似藥;此外更展開雙特異性ADC新藥TSY-310的研發,專攻實體腫瘤,積極佈局高價值的抗癌藥物市場。
APNT® Programs
APNT®奈米微粒製劑技術是以鹽與糖作為研磨介質,在溫和環境下將難溶性藥物粒徑縮小至奈米級,不僅能避免交叉污染、維持藥物純度,更能大幅提升吸收率與身體可用率。
APNT®應用廣泛,適用劑型涵蓋眼藥水、口服製劑、吸入劑以及局部注射劑等。從台新藥指標性眼科研發專案APP13007成功取得美國FDA藥證並上市,明確證實了APNT®奈米技術平台具備高度的「可成藥性」且獲得國際肯定。請參考我們的研發專案以了解更多。

眼科術後發炎及疼痛治療 |APP13007

APP13007是以APNT®技術開發的強效類固醇奈米懸浮滴眼液,主治眼科術後發炎與疼痛。臨床試驗證實其兼具強效與低副作用的優勢,眼壓升高風險優於其他類固醇眼藥,且每日只需點眼兩次、每次一滴,大幅提升患者用藥順從性。
研發進度上,目前APP13007已成功取得美國FDA藥證並上市、成功取得加拿大Health Canada藥證,完成全球多國市場授權。
眼科感染症新藥 |APP13002

APP13002為以APNT技術開發之奈米懸浮滴眼液,具廣效抗菌與抗發炎作用。在治療細菌性結膜炎、角膜炎、瞼緣炎及瞼板腺功能障礙具有潛力。
APNT®共同開發專案

APNT採委託與共同開發模式,廣泛適用於眼藥、口服、吸入劑及局部用藥等多元劑型。歡迎致力於研發新藥的生技醫藥廠商與各大研究機構主動洽詢台新藥,共同探索技術合作的無限可能!
ADC研發專案
台新藥的ADC研發聚焦於市場價值已經充分驗證之ADC生物相似藥以及高度創新的雙特異性ADC新藥。
- TSY-110與TSY-120:分別為Kadcyla®與Enhertu®的生物相似藥。兩專案與台康生技及台耀化學結盟開發,主攻HER2陽性與低表達性乳癌等HER2靶點癌症,其中TSY-110預計於2026年展開臨床試驗。
- TSY-310:為首創的雙特異性ADC新藥,精準鎖定EGFR與ROR1雙靶點。專攻非小細胞肺癌等實體腫瘤,具克服抗藥性的潛力,解決腫瘤治療中未被滿足的醫療需求。

Kadcyla® 生物相似藥 |TSY-110

TSY-110是一個標靶HER2陽性惡性腫瘤的ADC(抗體藥物複合體)生物相似藥。結合台康生技的抗體與台耀化學CDMO生物共軛平台,與原廠藥物具高度生物相似性。TSY-110目標為成為第一個全球上市的生物相似藥,以提供患者及健康保險提供者一樣有效且更經濟的治療方案。
Enhertu® 生物相似藥|TSY-120

TSY-120是台新藥、台康生技與台耀化學共同開發的ADC生物相似藥,其參照藥物為Enhertu®。此藥物主攻HER2陽性與弱陽性乳癌。研發目標是成為全球首款上市的Enhertu生物相似藥,為患者提供療效等同且更具經濟效益的治療選擇。
新世代雙特異性Fc融合藥物複合體 (Bispecific ADC)|TSY-310

TSY-310是創新的雙特異性ADC新藥,精準鎖定EGFR與ROR1雙靶點,對非小細胞肺癌等實體腫瘤深具治療潛力。其體積僅約傳統抗體一半、滲透力強,有望克服現行療法的抗藥性難題,滿足實體腫瘤治療中未被滿足的醫療需求。
其他專案
抗感染研發專案| TSY-210
台新藥的抗感染研發專案TSY-210的候選藥物具備廣譜的抗菌能力,包括院內感染及具微生物抗藥性(anti-microbial resistance, AMR)的菌株。TSY-210對WHO及美國CDC所指定的22項重要AMR病原體其中的9項的感染有治療潛力。




